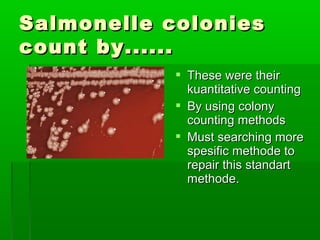
Salmonelle colonies
count by......
             These were their
              kuantitative counting
             By using colony
              counting methods
             Must searching more
              spesific methode to
              repair this standart
              methode.

This document provides an introduction to biochemistry for students. It discusses that biochemistry deals with the organic compounds inside living cells called protoplasm. Students are expected to learn the basic structures and functions of primary organic compounds like carbohydrates, lipids, proteins, and nucleic acids. Carbohydrates are polymers of monosaccharides joined by condensation reactions. Lipids are made of hydrocarbon chains, often attached to a glycerol molecule. Proteins are polymers of amino acids joined by peptide bonds. Nucleic acids are polymers of nucleotides.